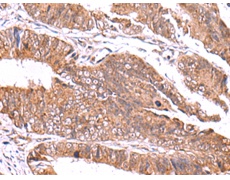
一抗

中文名稱: 兔抗GATM多克隆抗體
相關(guān)類別: 一抗
|
Background: |
This gene encodes a mitochondrial enzyme that belongs to the amidinotransferase family. This enzyme is involved in creatine biosynthesis, whereby it catalyzes the transfer of a guanido group from L-arginine to glycine, resulting in guanidinoacetic acid, the immediate precursor of creatine. Mutations in this gene cause arginine:glycine amidinotransferase deficiency, an inborn error of creatine synthesis characterized by cognitive disability, language impairment, and behavioral disorders. |
|
Applications: |
ELISA, IHC |
|
Name of antibody: |
GATM |
|
Immunogen: |
Fusion protein of human GATM |
|
Full name: |
glycine amidinotransferase |
|
Synonyms: |
AT; AGAT; CCDS3 |
|
SwissProt: |
P50440 |
|
ELISA Recommended dilution: |
5000-10000 |
|
IHC positive control: |
Human colorectal cancer |
|
IHC Recommend dilution: |
50-300 |

 購物車
購物車 幫助
幫助
 021-54845833/15800441009
021-54845833/15800441009